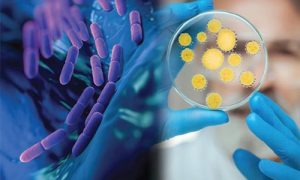

Odgovor je “prost” … svaka koja je u tom trenutku dostupna. Činjenica da imamo “švedski sto” vakcina na raspolaganju i još da ih je u dovoljnoj količini da ih svako ko to želi primi, dodatno pojačava dilemu. Za razliku od nas mnogi u Africi željno iščekuju da im stigne bilo koja vakcina. Nije im bitno ni koliko je efikasna samo da ih koliko-toliko zaštiti. Podsetimo se, pandemija će proći tek kada u celom svetu ne bude više dovoljno “domaćina” da se virus “bahati”.
No ako već imamo taj “luksuz” evo i par reči o efikasnosti i efektivnosti vakcina.
Efikasnost je termin koji se koristi tokom kliničkih ispitivanja vakcina. Pokazuje koliki je procenat onih koji po prijemu vakcine neće oboleti kada dodju u dodir sa “divljim” virusom. Svetska zdravstvena organizacija je kao limit odredila 50% odnosno, samo vakcine čija je efikasnost viša od 50% mogu da se prihvate za primenu u svetu.
Ispostavilo se da su rezultati vakcina razvijenih novim tehnologijama znatno bolji. Išli su i do 95% a čak i one manje efikasne su negde oko 75%. Medjutim ovo su istraživanja u prilično kontrolisanim uslovima (gde su pojedinci obično odgovorniji od prosečnog stanovništva) tako da se po otpočinjanju kampanje vakcinacije “meri” jedan drugi pokazatelj – efektivnost.
U suštini, efektivnost se računa isto kao i efikasnost, samo na osnovu podataka sa terena. Efektivnost je nešto niža nego efikasnost ali čak i tu se kreće od 70% do 90% za sve vakcine.
Iako su u pitanju nijanse i nekada lekari mogu preporučiti odredjenu vakcinu za odredjene kategorije bolesnika (zbog njihovog sastava i uticaja na pridružene bolesti i stanja) efektivnost vakcina kreće od američko-nemačke Fajzer vakcina (Pfizer-BioNTech), zatim slede ruski Sputnjik (Sputnik V) i britansko-švedska AstraZeneca a najmanje efektivna je kineska Sinofarm vakcina (Sinopharm).
Napominjem da su u pitanju male razlike i da to to Sinofarm vakcinu ne čini nedovoljno efikasnom protiv KOVID infekcije. Njena nesreća je što su vakcine razvijene novijim tehnologijama ostvarile značajno veću efektivnost neko što je bilo ko pre početka istraživanja očekivao.
Čisto za poredjenje vakcina protiv sezonskog gripa obično ima efektivnost od 40% do 60% (i u sezoni kada dostigne 60% svi su prezadovoljni) pa opet i tako “slabo efektivna” sprečava ogroman broj smrt i u globalnoj upotrebi je decenijama u nazad.
NITAG (Nacionalno telo za imunizaciju) u svojoj prvoj preporuci o trećoj dozi, savetovalo da se izabere jedna od iRNK vakcina (trenutno je kod nas jedino raspoloživ Fajzer ali bi uskoro trebale da stignu isporuke i američke Moderna vakcine). Kasnije je ova preporuka proširena na sve raspoložive vakcine.